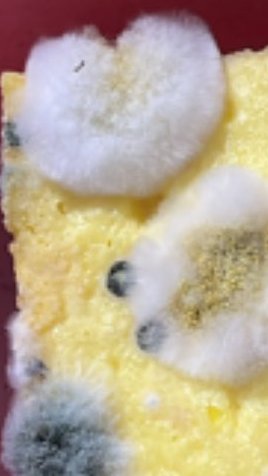
Amanda Brownies tweet media

پن کیا گیا ٹویٹ
pipopp
19.1K posts


@ramramyeon_ Gilaa kerenn bgt lukh nderr, dulu kesmas jurusan impian ku heuheu
Indonesia


Alhamdulillah guys aku juga diterima di PTLN di hari yg sama😭😭😭💚💚💚

wawa²⁶@sooncamabaui
ALHAMDULILLAH YA ALLAH SNBP BIRU😭😭😭 MASIH GA NYANGKA YA ALLAH😭😭😭😭😭💙💙💙💙
Indonesia